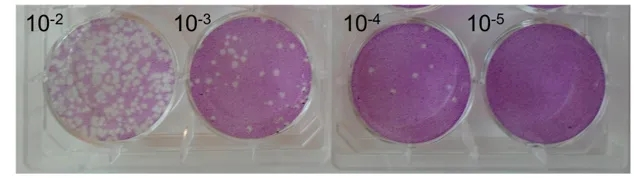
from clipboard from clipboard

1
ASFV在不同溫度下的研究
有許多研究已經(jīng)證明了非洲豬瘟病毒在土壤、飼料、豬肉、糞便等基質(zhì)中的存活情況。此前,有研究發(fā)現(xiàn),在實(shí)驗(yàn)條件下,感染劑量的非洲豬瘟病毒可能存在于液體環(huán)境中,但非洲豬瘟病毒在真實(shí)水體環(huán)境中的存活能力,尚未得到很好的研究。
最近,英國布萊特研究所的研究人員對(duì)非洲豬瘟病毒在不同溫度條件下,在河水中的穩(wěn)定性進(jìn)行了評(píng)估。研究人員在泰晤士河及其主要支流沿岸不同地點(diǎn)采集水樣,并將ASFV BA71V毒株(基因?型)毒株接種到水樣中,分別在4℃,15℃和21℃下進(jìn)行培養(yǎng),并在培養(yǎng)第0、7、14、21和42天后,使用空斑測定法計(jì)算各樣本中的病毒滴度。
結(jié)果發(fā)現(xiàn),在4℃的環(huán)境溫度下培養(yǎng)21天,各組的病毒滴度沒有顯著差異,但隨著培養(yǎng)時(shí)間延長和培養(yǎng)溫度的升高,病毒的穩(wěn)定性和感染性都將降低。與蒸餾水對(duì)照組相比,環(huán)境溫度升高到15℃和21℃時(shí),天然河水樣本中的病毒滴度,下降更為明顯。平均而言,ASFV BA71V毒株在4℃環(huán)境溫度下,培養(yǎng)42天,仍保持傳染性,但溫度升高至15℃和21℃時(shí),病毒的穩(wěn)定性下降,分別縮短為28天和14天。病毒在15°C和21°C下孵育28天后,滴度會(huì)出現(xiàn)4log10的降低,此時(shí)病毒被認(rèn)為已失去傳染性。

圖1 泰晤士流域地圖,采樣點(diǎn)位置
圖2 VERO病毒接種試驗(yàn)

圖3 病毒在4℃、15℃和21℃水樣中隨時(shí)間的滴度變化
2
60℃加熱處理2小時(shí),
非洲豬瘟病毒依然存活且發(fā)生致弱

發(fā)表于《Viruses》雜志上的一篇文章表明:對(duì)格魯吉亞2型ASFV在60℃環(huán)境下加熱2小時(shí)后,在肺泡巨噬細(xì)胞上無法培養(yǎng)出病毒,但將加熱后的病毒接種豬只后,病毒竟然復(fù)活了,但復(fù)活后的病毒的毒力變?nèi)趿恕?/p>
原文表示,在嘗試通過熱處理滅活Georgia 2007/1菌株時(shí),研究團(tuán)隊(duì)偶然產(chǎn)生了一種名為ASFV-989的減毒株。與Georgia相比,ASFV-989毒株基因組在MGF 505/360的5'端編碼區(qū)缺失了7458個(gè)核苷酸,這使得DIVA PCR系統(tǒng)的建立成為可能。在豬肺泡巨噬細(xì)胞中,ASFV-989和Georgia株的復(fù)制動(dòng)力學(xué)相同。在體內(nèi),接種了ASFV-989毒株的無特異性病原體(SPF)豬,無論是肌肉注射還是口鼻注射,都表現(xiàn)出短暫的高溫和輕微的生長性能下降。
用ASFV-989株感染動(dòng)物的病毒血癥比接種格魯吉亞株低100~1000倍,并產(chǎn)生快速的抗體和細(xì)胞介導(dǎo)反應(yīng)。在接種ASFV-989疫苗的豬中,格魯吉亞毒株攻毒2或4周后,沒有記錄任何癥狀,也沒有檢測到攻毒株的病毒血癥。這些結(jié)果表明,ASFV-989毒株是一種有希望的非轉(zhuǎn)基因候選疫苗,可用于肌肉注射或口鼻注射。
參考來源:DOI: 10.3390/pathogens12081022,
https://pubmed.ncbi.nlm.nih.gov/36560781/